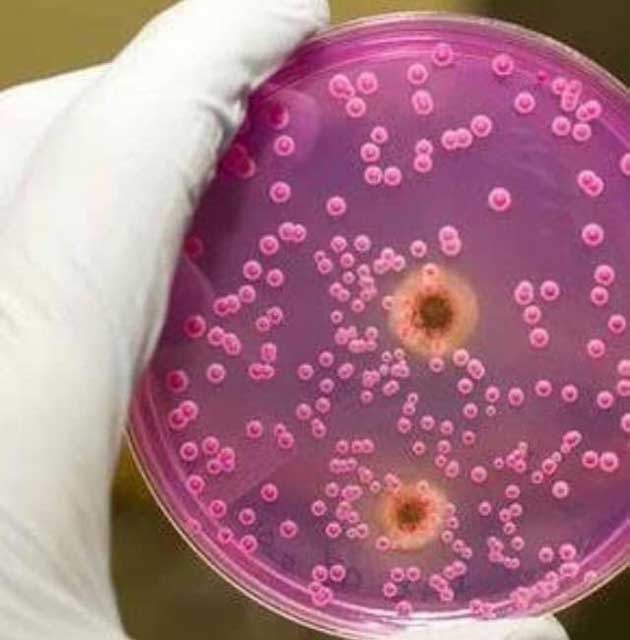

İTALYAN DOKTORDAN ŞOK İDDİA!*
*KANSER* KOLAYCA ORTADAN KALDIRILABİLEN BİR *MANTARDIR* !
*Çare : KARBONAT*
Bu tedavi hiç zararlı değildir ve kaybedecek bir şeyin yok.
- Zamanımızın en zor ve ölümcül hastalığının gerçek tedavisini bulmak, ahlaki ve etik sorumluluğumuzdur! diyor, *ONK. Dr. Simonchini.*
*KANSER BİR MANTAR!*
- Yaklaşık yüz yıl önce, kansere genlerin yanlış çalışmasından kaynaklanan büyük bir teori vardı; bu da hastalığın hücre içi olduğu anlamına geliyor. Bununla birlikte, bence kanser mantar enfeksiyonu ve özel bir hücresel olgu, diye de ekliyor Dr. Simonchini.
Bu iddiası tıp camiasında şok etkisi yaratıyor.
Peki *CANDİDA MANTARI* nedir?
Bitki dünyasında, tümör mantar enfeksiyonlarından kaynaklanır ve insanlarda da aynısı gerçekleşir.
Mantarlar daima onlarla birlikte bir tümör taşırlar -bu çalışmalarla kanıtlanmıştır.-
Bununla birlikte, bilim adamları hastalık ortaya çıktıktan sonra geliştiklerini düşünüyorlar.
Simonchini;
*Mantarlar kanser yaratır, bağışıklık sistemimizi zayıflatır ve ardından tüm vücuda saldırır*.
Her *kanser* türü, çeşitli çalışmalarla doğrulanan *Candida mantarından* kaynaklanır.
Zamanla dokularımız zayıflar ve yorgun olurlar ve tanımlanamayan hücreler üretmeye başlarlar, der.
Simonchini‘ye göre, kanser deforme olmuş hücrelerin toplandığı ve kolonileri oluşturduğu bir yapıdır.
Peki çare nedir?
*KARBONAT*..
Simonchini;
- Bu mantar kolonilerine saldırabilecek şeyleri tespit ettim.
*Kanser* için, *karbonat* ve *iyot tentürü cilt kanseri* için en iyi madde, diyor.
Pek çok çalışma, *karbonatın* *kansere karşı* hücresel hareketi olduğunu doğrulamıştır.
Ya tedavi?
- Tedaviyi hastalarımda 20 yıldan fazla kullandım. Bu hastaların birçoğu, doktorlar onlara şans tanımadıklarında bile, hastalığı iyileştirdi.
*Bir tümörü ortadan kaldırmanın en iyi yolu*, *sindirim kanülleri* için *lavman*, *beyin ve akciğer tümörleri için intravenöz enjeksiyon* ve *üst solunum sistemindeki tümörler için inhalasyon* olarak uygulanabilen *karbonat* ile temasa girmektir.
*Meme, lenf sistemi ve subkutan tümörler lokal perfüzyon ile tedavi edilebilir.*
*İç organ tümörleri, direkt olarak arterlere uygulanarak karbonat* ile tedavi edilmeli ve her kanser türünün uygun dozu ile tedavi edilmesi önemlidir, diyor.
*Karbonatın YAN ETKİSİNİN SUSUZLUK ve ZAYIFLAMADAN başka bir şey olmayacağını ekliyor.*
Özetle..
Yukarıdaki yazı biraz bilimsel o yüzden size daha açık bir şekilde özetleyelim.
Kanseri oluşturan şartları bertaraf etmek veya oluşanı tedavi etmek için;
*Her gün 1-2 ÇAY KAŞIĞI KARBONATI bir su bardağı suya karıştırıp içeceksiniz..*
Olay bu kadar basit..
Bunu bulan doktorun başka yöntemleri de var.
*Olayın özü vücudun alkali hale getirilmesi..*
*Kanserin* asıl sebebi *mantarlar*.
*Candida* yani.
*YEDİĞİMİZ, İÇTİĞİMİZ GENETİĞİ OYNANMIŞ YİYECEKLER, İŞLENMİŞ GIDALAR, CİPSLER, KOLALAR HEPSİ ‘ASİDOZ’A YOL AÇIYOR.*
*ASİDOZ DEMEK; HÜCRELERİN OKSİJEN ALAMAMASI demektir..*
Oksijen alamayan hücre noluyor?
*ÇÜRÜYOR* ..
*Çürüyen hücrede de mantar oluşuyor.*
Mantarların yayılmasını önlemek için, vücut mantarların etrafını sarıyor ve bu da tümörleri oluşturuyor.
Doktorlar tümörü kesip aldıklarında mantarlar diğer yerlere de yayılıyor.
Tüm bunları günlerdir yaptığım araştırmalarda izledim.
*Asidozun* çaresi ne niye baktığımda vücudun *PH seviyesinin* yükseltilmesi gerektiğini okudum.
*PH NASIL YÜKSELİR?* diye baktım;
*KARBONATLI SU BU İŞİ YAPIYOR..*
*KARBONATIN MİDE ÜLSERİ olanlar hariç zararı yok.*
Siz de araştırın göreceksiniz..
Olay bu kadar basit aslında.
*HASTA OLMAMAK İÇİN HER GÜN 1 ÇAY KAŞIĞI KARBONATLI SU İÇMELİSİNİZ.*
Bunu, sabah - akşam 1 bardak suya yarım çay kaşığı karıştırıp 3 dak. bekleyip iyice karışmasını bekleyin, sonra tekrar karıştırıp için.
Her beden ve her bedenin göstereceği tepki farklı olucaktır.
Çünkü herkesin farklı beslenme biçimi var.
Bundan dolayı herkesin kendi bedenini dinleyip buna bağlı olarak karbonat miktarını ayarlaması gerekir.
*UNUTMAYIN* ; *karbonatı eczaneden* alacaksınız, *KABARTMA TOZUNU İÇMEYİN!*
*ÖNEMLİ NOT:*
*Eğer yüksek* tansiyonunuz varsa ya da yaşlıysanız *karbonatlı suyu içtikten sonra 10 - 15 dak. uzanıp dinlenin.*
Bazı insanlarda tansiyonda yükselme yaratabilir ama bu kısa sürer.
*Öznur TANAL*
*KANSER* KOLAYCA ORTADAN KALDIRILABİLEN BİR *MANTARDIR* !
26 Ocak 2019 - 21:53
Son Yazılar
- KAN GURUPLARI NESEBİ İSPAT EDER - 20 Şubat 2026
- Irak'lı Şii araştırmacı Ensar el-Sadr'ın ibretlik yazısı: - 02 Aralık 2025
- B. BELEDİYESİNDEN YAKIN TARİHİMİZDEKİ İHANETE HİZMET - 01 Aralık 2025
- 17 yıllık ruh halim - 20 Kasım 2025
- BÜTÜN KİMLİK VE GÜVENLİK BİLGİLERİMİZ ÇETELERİN ELİNDE - 30 Haziran 2025
- Bazen yanıldığımızı çok sonradan öğreniriz - 01 Ocak 2025
- KEŞKE ALLAH cc. OLMASAYDI - 23 Kasım 2024
- Unutulma hakkı ile ilgili olarak verilen Avrupa Birliği Adalet Divanı - 27 Ekim 2024
- 1967-1974 Komünistlerinin çoğu Suriye'de komünist oldu - 14 Ekim 2024
- TÜRKİYEDE SERBEST PİYASA EKONOMİSİ UYGULANMIYOR. - 29 Haziran 2024
- HZ. AİŞENİN EVLİLİĞİ ÜZERİNE YAPILAN YORUMLAR - 22 Haziran 2024
- MÜSLÜMANIM DİYORSUNUZ, BUNLARIDA DİYEBİLİYORMUSUNUZ? - 28 Mayıs 2024
- Tarihten geldiği söylenen bir yalan ve Türk düşmanlıkları - 21 Mayıs 2024
- MÜSLÜMANLARIN EVLİLİĞİNİ İSTİSMAR EDENLER - 18 Mayıs 2024
- Sülün Osman Dolandırıcılar kralıydı - 28 Nisan 2024
- Ahit Sandığı (Tevrat ) MÖ. 587 yılına kadar Beytülmakdis'te kaldı. - 05 Nisan 2024
- Ahit Sandığı (Tevrat ) Sekine - 05 Nisan 2024
- HZ.MUSA'NIN AHİT SANDIĞI ANTAKYA'DA MI? - 05 Nisan 2024
- 1. Dünya savaşında Kudüs halkı Osmanlı İle.. - 16 Ekim 2023
- Filistin toprakları kimin? - 11 Ekim 2023

